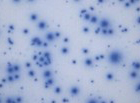
Icon

Let Our CRO Team Fast-Track Your ELISA Assays
As pioneers in the immune monitoring arena, the CTL Contract Research Laboratory (CRO) Services team has more than a decade of proven expertise in performing high-throughput immunological assays, including ELISA.
Our CRO has developed and validated numerous customized ELISA assays for pharmaceutical and biotechnology clients spanning diverse antigenic systems including AAV, SARS, and cancer antigens, just to name a few. We have successfully deployed such validated assays in clinical trials, translational and preclinical studies, and commercial CLIA/CLEP-LDT assays.
ELISA is an effective quantitative assay to assess immunogenicity. For a more comprehensive analysis, we highly recommend coupling ELISA with other immunoassays like ELISPOT, CBA etc.
Let us help to reach your project milestones faster. Reach out to our experienced ELISA team today so we can assist you!

ELISA Optimization, Validation, and Sample Testing Services
Our CRO can develop and validate a wide array of customer-specific ELISA assays to assess various analytes including antigens, antibodies (and their isotypes), or cytokines and more.
ELISA-Based Diagnostic Tests
Our CLIA/CLEP-certified contract laboratory specializes in general/diagnostic immunology tests tailored to our clients’ needs, in accordance with FDA Bioanalytical Method Validation Guidance for Industry.
We currently offer diagnostic ELISA assays (LDT):
- ELISA-based detection of AAV9 capsid IgG antibody (TAb (IgG)) in serum, plasma and other fluid specimens, the ADA assay LDT NYS CLEP approved Project ID: 62201 PFI: 9337.
- Anti-AAV IgG ELISA e.g. diverse serotypes and species (validated).
- Human anti-SMN IgG ELISA (validated).
- Human anti-SARS-CoV-2 IgG ELISA (validated).
Our optimized/validated assay services have helped many Pharma and Biotech clients evaluate immunogenicity in preclinical studies and clinical trials for example in oncology, gene therapy, infectious disease systems, vaccines, and immunotherapeutics to name a few.